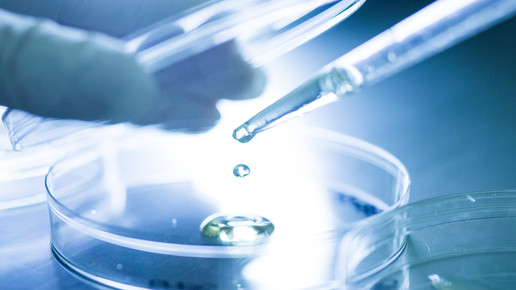

Aboca: Gewinn und Gemeinnutz
Der italienische Hersteller Aboca hat seine Unternehmensform von einer Aktien- in eine Benefit-Gesellschaft umgewandelt. Die Firma schreibt damit in ihrer Satzung zusätzlich zur Erzielung von Gewinnen auch Zwecke des Gemeinwohls fest. Die neuen Ziele werden von externen Prüfern auditiert.
Die Rechtsform Benefit-Gesellschaft (B-Corp) stammt aus den USA und ist in Italien seit 2016 anerkannt. In diesen Betrieben muss ein Verantwortlicher benannt werden, der die Tätigkeiten jährlich transparent darstellt. Aboca will laut eigenen Angaben unternehmerisches Handeln mit dem Engagement für das Gemeinwohl verbinden. Anders als eine gemeinnützige GmbH (gGmbH) darf eine B-Corp Gewinne an die Gesellschafter ausschütten.
Der Hersteller will das Gemeinwohl mit vier Bereichen stärken: Forschung und Innovation, Verbesserung der Umwelt, Kultur und Gemeinschaft sowie Wertschätzung der Menschen. „Die Werte, die wir verfolgen, sind seit jeher Teil unserer DNA“, sagte Massimo Mercati, Verwaltungsratsvorsitzende und Sohn des Firmengründers Valetino Mercati. Wert für die Gesellschaft zu schaffen, sei die grundlegende Voraussetzung, die es Unternehmen wie Aboca ermögliche, sich am Markt zu behaupten.
Aboca wurde vor 40 Jahren gegründet. Die Firma ist nach dem Ort in der Toskana benannt, der auch der Firmensitz ist. Der Hersteller mit rund 1300 Mitarbeitern baut selbst rund 70 verschiedene Heilpflanzen auf rund 1200 Hektar an. Das Land wird laut Firmenangaben nach zertifizierten Biotechniken bewirtschaftet. Die Produkte werden selbst entwickelt und hergestellt. Der Jahresumsatz liegt bei rund 130 Millionen Euro.
Von Beginn an setzte Mercati auf nachhaltig hergestellte Produkte. Die Rohstoffe werden biologisch angebaut und mit einem Anteil von rund 30 Prozent an erneuerbaren Energien hergestellt. Die Umverpackungen bestünden aus recycelbaren Materialien. Trinkwasser gibt es für das Team ausschließlich in Glasflaschen, Plastikgeschirr ist tabu und die Firma setzt auf lokale Lieferanten, um weite Transportwege zu sparen.
Hierzulande ist Aboca seit Oktober 2016 mit einer eigenen Niederlassung aktiv. Im Außendienst sind rund 15 Mitarbeiter tätig. Zum Sortiment gehören zwölf Marken wie Grintuss, Leviaclis, Colilen IBS, Fitomagra Libramed, Fitostill Plus und Neobianacid in den Indikationen Erkältung, Magen-Darm, Gewichtskontrolle, trockenes Auge und Stoffwechsel. Für Sanofi machte Aboca zuletzt eine Ausnahme und war als Lohnhersteller aktiv. Das Medizinprodukt Mucosolvan Phyto Complete wurde von Aboca entwickelt.
Für das Deutschlandgeschäft ist Jan Reinfrank zuständig. Weitere Niederlassungen gibt es in Frankreich, Polen und den USA. Die Produkte werden exklusiv in rund 20.000 Apotheken in 14 Ländern vertrieben. In Italien gehört Aboca laut eigenen Angaben zum viertgrößten OTC-Hersteller nach Angelini, Sanofi und GlaxoSmithKline (GSK).

APOTHEKE ADHOC Debatte